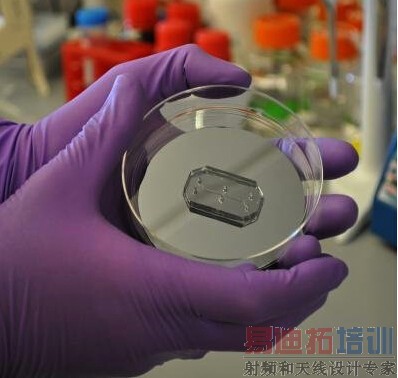
1.jpg

- 易迪拓培训,专注于微波、射频、天线设计工程师的培养
魔幻现实主义科技:存在于芯片中的人体器官
新药研发和试验是一个漫长且耗资巨大的过程。为了制造出前景无限的化合物或者分子,科学家需要进行海量研究。此后,他们还要在动物身上进行试验,如果安全有效则会在人体上进行临床试验。在这个过程中,科学家需要观察药物的安全性和疗效,以及合适的用药剂量。
过去很长一段时间内,科学家一直努力试图简化或者加速这个流程。为此,他们在小型芯片上模拟出人体器官(人工排列人体活细胞,使其模拟完整器官的功能和结构)。这就是所谓的“芯片仿真人体器官系统”(organ-on-a-chip systems)。在未来的某一天,这个系统也许会代替动物试验,同时减少人体试验所需要的步骤和时间。《Nature News》杂志的报道称,这种充满未来主义风格的愿景正在慢慢变成现实。
这是一个“真实”的肺脏,但它不是真的
计算机的微芯片由硅树脂材料打造而成,而芯片仿真人体器官也建造于这样的材料之上:科学向经过专门蚀刻打造的模具中浇筑液态硅胶,模具上有很多槽道,因此硅树脂芯片上也就多了很多槽道。在这些槽道里,科学家安置培育了很多人体细胞。这些细胞从槽道的底部生长,而培养液则会在槽道中流动以便为细胞输送营养。于是,科学家就可以在培养液中加入等待测试的新药或者其他物质,观察其与细胞结合之后的情况。
一般而言,最基础的芯片仿真人体器官仅培育一种类型的细胞。为了模拟不同器官一起工作的状态,科学家需要为基础版本芯片仿真人体器官增加新的功能和特性。比如哈佛大学维斯生物工程研究所(Wyss Institute for Biologically Inspired Engineering)研发的芯片仿真肺部器官复杂度更高,可以模拟具有呼吸功能的肺部。在他们的实验中,工作人员用薄膜隔开了硅树脂芯片上的槽道,使其构成了两个隔室。接着,他们在每个隔室中放入了两种不同类型的肺部细胞:一种可以与薄膜顶部空气完成气体交换,一种可以与隔室底部血液完成气体交换。
魔幻现实主义科技:存在于芯片中的人体器官

为了让这个芯片仿真肺部器官具备呼吸功能,科学家不断向隔室顶部输送空气,同时在隔室底部用液体模仿人体的血液流动。这样一来,他们就可以观察空气中哪种分子可以进入肺部和血液中。这个过程模拟的其实就是人体从空气中获取氧气,然后将氧气储存于血液中并输送给全身细胞。
在另一个实验中,哈佛大学的科学家还展示了一种抗癌症药物对人体的侵害——这种药物会导致液体从薄膜的血液一侧流向空气一侧。在人体中,这种药物会使患者肺部充满液体,从而导致呼吸困难。
生物技术公司和制药公司之间的合作为我们带来了芯片仿真人体器官系统,以便加速药品测试过程。据报道,荷兰生物技术公司Mimetas研发了一种芯片仿真肾脏器官,而三家制药公司已经准备好利用这款产品测试自己的新药。
另外,强生也已经对外宣布,计划利用美国马萨诸塞州生物技术公司Emulate的芯片仿真人体器官系统进行药物试验。值得一提的是,Emulate公司隶属于哈佛大学维斯生物工程研究所。报道称,强生已经开始在模拟人体血栓的芯片仿真人体器官系统上测试药物,还计划利用芯片仿真肝部来观察药物对人体肝脏是否有损伤。血栓和肝脏损害是药物常见的潜在副作用,通过芯片仿真人体器官,我们就能更早地发现药物的潜在危害。
芯片仿真人体器官:潜力无限的未来技术
从目前的情况来看,芯片仿真人体器官系统具有极大的潜力,能从很多方面改进现行的药物检测流程。
首先,在药物试验中,芯片仿真人体器官明显优于培养皿。科学家在肺癌的芯片仿真人体器官模型中进行药物检测时发现,芯片仿真人体器官系统预测的最有效剂量和人体临床检测中发现的最有效剂量最为接近,预测结果比培养皿中细胞常规测试中的预测结果要精准很多。这是因为,培养皿中的细胞都平铺在一个平面上,而芯片仿真人体器官系统能够更好地再现人体的三维机构。对于研究类似于大脑这样的复杂器官或者胎盘这样很难在其工作时开展研究的器官而言,重现三维结构极为重要。
另外,这项新的技术在精确度上也优于动物试验。利用芯片仿真人体器官系统检测新药得到的结果比利用动物模型检测得到的结果精确度更高。动物研究得出的检测结果可能具有误导性:有的药物在动物身上出现不好的副作用,但是在人体上却没有这样的问题(扼杀了一款优秀药物步入市场);有的药物在动物身上没有任何问题,但是在人体却会产生副作用(导致昂贵的临床试验失败,或者更糟糕的情况下会导致公众遭受药物有害的副作用)。
魔幻现实主义科技:存在于芯片中的人体器官
当然,作为一项研发中的技术,芯片仿真人体器官系统还有一些重大障碍需要克服。首先,芯片仿真人体器官的复杂度终究比不过人体真实器官,而且该系统也无法模拟真实器官被人体内其他不相邻器官干扰影响的状态。比如,芯片仿真人体器官可能无法完全模拟激素(例如胰岛素)改变人类肌肉中细胞行为的复杂模式。另外科学家还在进行测试,试图查清现有的药物是否能以我们期望的方式在芯片仿真人体器官系统上发挥作用。
不过这些障碍并不妨碍人们对新技术的热情。很多制药公司和美国国立卫生研究院下属的美国国家转化科学促进中心(NCATS)也参与了研发。据悉NCATS投入大量资金,资助了11款芯片仿真人体器官系统的开发过程。如果芯片仿真人体器官能够证明自身在测试药物过程中的优点,那么这款技术便能提高药物研发的速度、精准度和性价比。这将是医学领域的重大改变,而且正在逐步变成现实。


